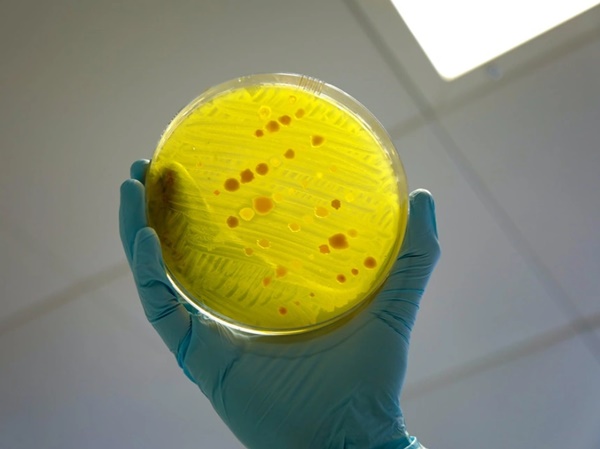

Kháng thuốc kháng sinh đã giết chết nhiều người hơn so với HIV hoặc sốt rét vào năm 2019. Theo Bloomberg, đây là kết quả được công bố trên tạp chí The Lancet đầu năm 2022, dựa trên phân tích toàn cầu. Năm 2019, ước tính trên toàn cầu có 4,95 triệu ca tử vong liên quan tình trạng kháng thuốc kháng sinh. Trong đó, nhiễm trùng do vi khuẩn kháng thuốc trực tiếp dẫn đến cái chết của 1,27 triệu người. Điều này khiến nó trở thành căn bệnh gây tử vong thứ 3 thế giới.
Dự báo 10 triệu người chết hàng năm vào 2050
Các nhà khoa học đã gióng lên hồi chuông cảnh báo trong nhiều năm về mối đe dọa nhiễm trùng khó chữa từ những vi khuẩn kháng ngay cả loại kháng sinh mạnh nhất. Nghiên cứu là nỗ lực tập hợp dữ liệu từ hàng trăm quốc gia, cho thấy số người chết vì kháng thuốc đã tăng nhanh hơn dự kiến.
Giáo sư Chris Murray, đồng tác giả nghiên cứu, Viện Đo lường và Đánh giá Sức khỏe, Đại học Washington, Mỹ, cho biết: “Các ước tính dự đoán vào năm 2050 sẽ có gần 10 triệu người mất mạng mỗi năm vì kháng kháng sinh. Chúng ta đang tiến gần hơn tới con số đó. Nếu không muốn bị bỏ lại trong cuộc đua chống kháng thuốc, chúng ta cần tận dụng dữ liệu này để hành động đúng và thúc đẩy đổi mới. Những dữ liệu mới của chúng tôi tiết lộ quy mô thực sự của tình trạng kháng thuốc trên toàn thế giới và lời cảnh báo rõ ràng cho việc chúng ta phải hành động ngay trước mối đe dọa”.

Kháng thuốc kháng sinh là nguyên nhân gây tử vong thứ 3 thế giới vào năm 2019, chỉ sau đột quỵ và bệnh tim. Ảnh: CIDRAP.
Theo bài báo, các nhà khoa học đã truy tìm những trường hợp tử vong có liên quan 23 mầm bệnh và 88 sự kết hợp giữa mầm bệnh và thuốc bằng dữ liệu từ 204 quốc gia và vùng lãnh thổ.
Hầu hết trường hợp tử vong là do nhiễm trùng đường hô hấp dưới như viêm phổi, nguyên nhân trực tiếp gây ra hơn 400.000 ca tử vong. Tiếp theo là nhiễm trùng đường máu, chiếm khoảng 370.000 ca tử vong, thứ 3 là nhiễm trùng vùng bụng như viêm ruột thừa, dẫn đến khoảng 210.000 ca tử vong.
Những tính toán cũng cho thấy chỉ kháng kháng sinh là nguyên nhân gây tử vong thứ 3 thế giới vào năm 2019, chỉ sau đột quỵ và bệnh tim.
Các quốc gia có thu nhập thấp và trung bình bị ảnh hưởng nặng nề nhất. Châu Phi cận Sahara và Nam Á có tỷ lệ tử vong trực tiếp ước tính cao nhất, với 24 và 22 ca tử vong trên 100.000 dân.
Trẻ em dưới 5 tuổi đặc biệt có nguy cơ mắc bệnh. Các nhà nghiên cứu ước tính chúng chiếm 1/5 số ca tử vong liên quan nhiễm trùng kháng thuốc kháng sinh trên toàn cầu.
Việt Nam là quốc gia có tỷ lệ kháng thuốc cao
Kháng thuốc kháng sinh (AMR) xảy ra khi vi khuẩn, virus, nấm và ký sinh trùng thay đổi theo thời gian và không còn đáp ứng với thuốc, làm cho bệnh nhiễm trùng khó điều trị hơn và làm tăng nguy cơ lây lan bệnh, bệnh nặng và tử vong.
Do tình trạng kháng thuốc, thuốc kháng sinh và các loại thuốc chống vi trùng khác trở nên vô hiệu và nhiễm trùng ngày càng trở nên khó hoặc không thể điều trị.
Tại Việt Nam, Tổ chức Y tế Thế giới xếp nước ta vào nhóm có tỷ lệ kháng kháng sinh cao nhất thế giới. Theo báo cáo tại hội nghị khoa học toàn quốc về hồi sức cấp cứu và chống độc 2017, từ năm 2009, số lượng thuốc kháng sinh ở Việt Nam bán ra ngoài cộng đồng đã tăng gấp 2 lần. Nguyên nhân chính là lạm dụng kháng sinh, có tới 88% kháng sinh tại thành thị được bán ra mà không cần kê đơn, ở nông thôn tỷ lệ lên đến 91%.
Việt Nam là quốc gia có tỷ lệ kháng thuốc kháng sinh cao. Ảnh: Freepik.
PGS.TS Lương Ngọc Khuê, Cục trưởng Cục Quản lý khám chữa bệnh (Bộ Y tế), cho biết trong khi nhiều quốc gia phát triển đang còn sử dụng kháng sinh thế hệ 1 có hiệu quả, Việt Nam đã phải sử dụng tới kháng sinh thế hệ 3 và 4. Đáng lo ngại hơn, ở nước ta đã xuất hiện một vài loại siêu vi khuẩn kháng lại tất cả loại kháng sinh. Phổ biến nhất là nhóm vi khuẩn gram âm đường ruột.
Các chuyên gia khuyến cáo để giảm tình trạng kháng thuốc, người dân chỉ dùng kháng sinh điều trị khi chắc chắn nhiễm khuẩn, không dùng bao vây; chọn kháng sinh theo kháng sinh đồ trong mọi trường hợp có thể, ưu tiên kháng sinh phổ hẹp, đặc hiệu; dùng kháng sinh đúng liều lượng, đủ về thời gian và phối hợp kháng sinh hợp lý; tuân thủ các biện pháp khử khuẩn và vô khuẩn, tránh lan truyền vi khuẩn đề kháng.
Theo Zing
